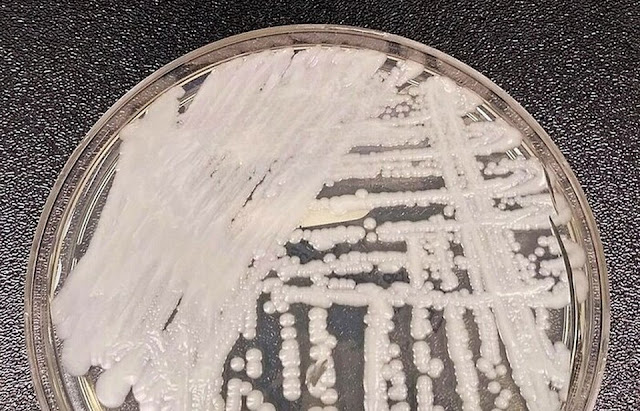

A Secretaria Estadual de Saúde de Pernambuco confirmou por
meio de nota, nesta quarta-feira (22), o 14º caso de colonização de Candida
Auris para a doença no Estado.
Segundo o estado, a paciente é uma mulher que está isolada
em um hospital da rede particular, localizado na Região Metropolitana do
Recife, para cuidar de uma doença ortopédica preexistente. A paciente não teve
a idade divulgada.
Ainda de acordo com o estado, Agência Pernambucana de Vigilância Sanitária (Apevisa), em apoio técnico à rede privada, chegou a monitorar outros quatro pacientes que tiveram contato com o 14º caso confirmado. Todos apresentaram resultados negativos para Candida e já receberam alta.
Dos 14 pacientes que testaram positivo em Pernambuco, sete
receberam alta hospitalar, dois permanecem internados no Hospital do
Tricentenário, em Olinda, e um em uma unidade particular. Quatro pacientes
vieram a óbito, decorrentes de patologias diferentes do superfungo.
Cerca de 4.222 amostras para a vigilância da Cândida Auris,
foram analisadas este ano, pelo Laboratório Central de Saúde Pública de
Pernambuco (Lacen-PE).
Tais análises incluíram casos suspeitos, contactantes dentro
do ambiente hospitalar e amostras de um estudo de prevalência, que não
demonstrou a circulação do fungo em hospitais da rede estadual.
A SES-PE ressalta que o Estado não registrou morte, até o
momento, causada por Candida auris.
''A Secretaria continua implementando medidas de prevenção e controle nos serviços de saúde hospitalares do estado e reforça a necessidade de vigilância e monitoramento contínuos em toda rede de atenção à saúde''.